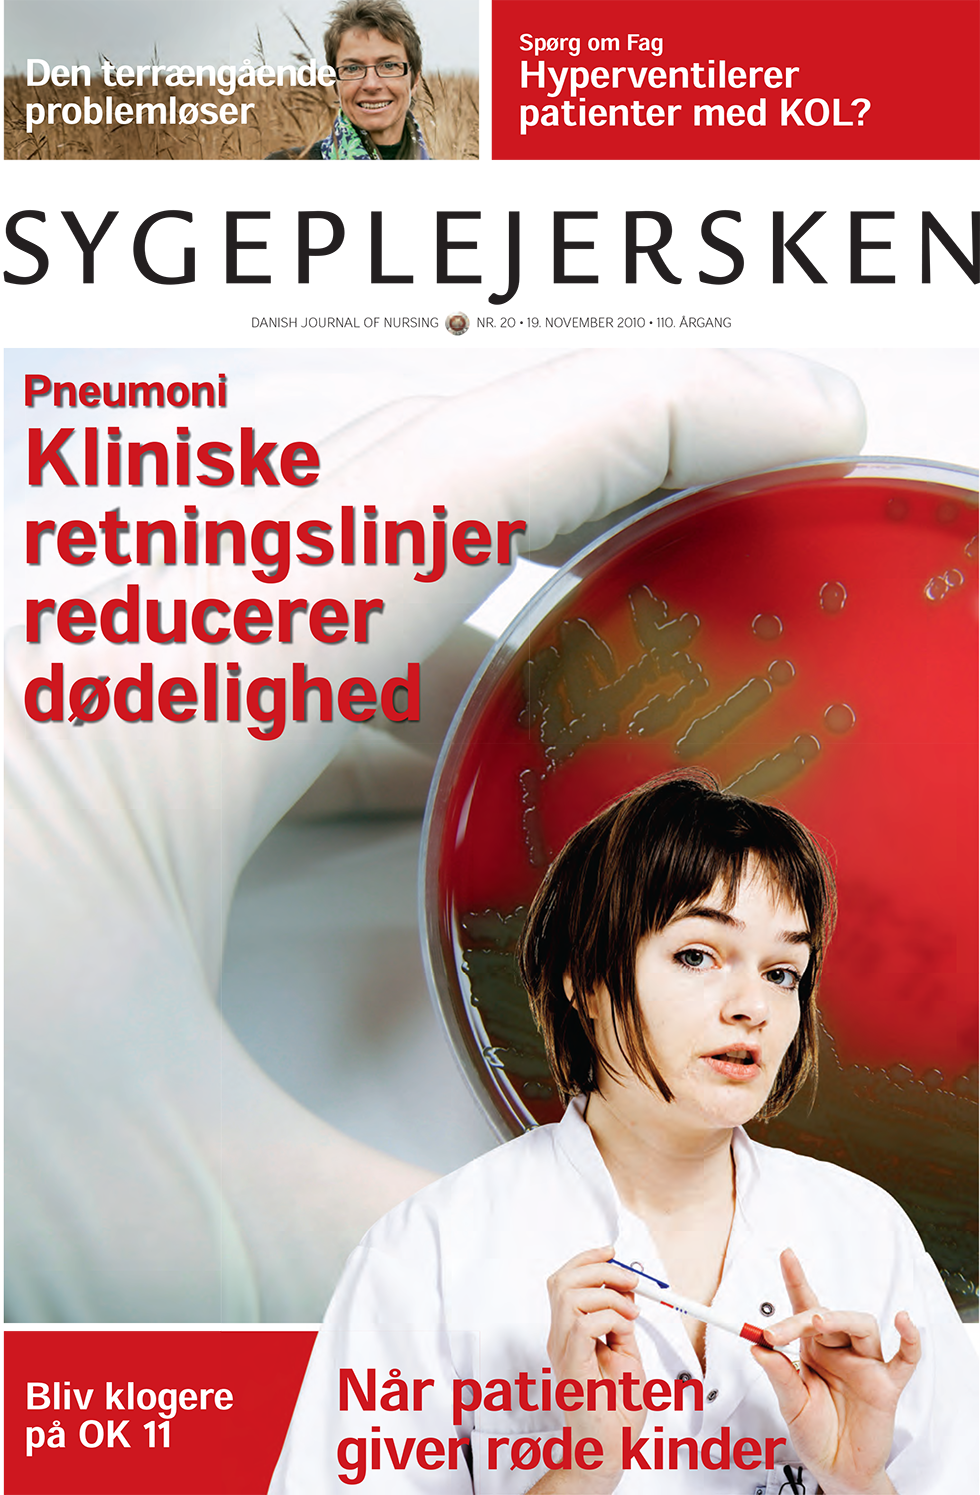
Sygeplejersken_2010_20 - magasinforsiden

Dilemma: Terapi af en art
Alette har taget en terapeutisk uddannelse i narrativ metode på et anerkendt uddannelsessted i Danmark. Nu vil hun gerne afprøve sine kundskaber i sundhedsplejen, hvor hun arbejder.

Alette har taget en terapeutisk uddannelse i narrativ metode på et anerkendt uddannelsessted i Danmark. Nu vil hun gerne afprøve sine kundskaber i sundhedsplejen, hvor hun arbejder.
En studerende oplever at få sine grænser overskredet ved et sengebad af en ældre mand.
Selv fik jeg først rigtigt øje på alternativ medicin, da jeg for godt 20 år siden fik diagnosticeret metastaseret brystkræft. Men det var ikke på den positive måde.
Læs de nyeste boganmeldelser.
For mange studerende er det første møde med en patients nøgenhed omgærdet af stor blufærdighed, som kan forstærkes af manglende erfaring og tabu om f.eks. nedre toilette. Nutidens forestilling om den perfekte krop spiller også ind, mener lektor.
Et sommerferiejob og 10 ugers klinik på et kardiologisk sengeafsnit har forvandlet Katja Pihl fra sippet til sej. Et par hurdler skulle overvindes, men nu kaster hun sig uden problemer over opgaver som patientbade og nedre toilette.
Øvelse gør mester, siger et ordsprog. Øvelse gør tryg, siger man på sygeplejeuddannelsen i Næstved. Her får de studerende den praktiske sygepleje i hænderne, allerede før de kommer ud i klinik. Konceptet kaldes skill lab.
Artiklen beskriver de kommunikative færdigheder, opvågningssygeplejersker lægger vægt på i mødet med den vågnende patient.
Artiklen beskriver effekten af intervention over for en række sygdomme i kombination med overvægt. Patienterne kommer fra hele Danmark og bliver behandlet på Livsstilscentret i Brædstrup, hvor de bliver indlagt
Ph.d. forsvar
Trods et markant fokus på støtteredskaber til implementering af en tværfaglig patientforløbsbeskrivelse for patienter indlagt med pneumoni på Århus Sygehus viser en audit stadig store variationer mellem afdelingers praksis.
To børn i hver skoleklasse har en forælder, der har eller har haft en psykisk lidelse. Psykiatrisk Team Vordingborg har gennem syv år arbejdet målrettet med familiesamtaler og samtalegrupper for børn af forældre med psykiske lidelser. Målet er at integrere patienternes børn i det samlede behandlingstilbud og forebygge stigmatisering af børnene.
60 sygeplejersker i Gynækologisk Klinik på Rigshospitalet har haft fokus på kommunikation. Viden fra undervisning og øvelser blev afprøvet gennem makkerpar over en uge. 76 pct. af sygeplejerskerne oplevede sig efterfølgende bedre rustede til bl.a. de svære patientsamtaler.
Grete Christensen er typen, der ikke kan lade være med at finde løsninger. Hvad enten det drejer sig om konflikter i en gruppe eller om en firhjulstrækker, der bryder sammen i Afrika. Sidste år blev hun formand for Dansk Sygeplejeråd.
Sygeplejerske Grethe Garonfolo, Århus, har udviklet en metode til supervision af personalet i plejeboligerne, hvor hun arbejder. Den hedder kvalitetsbesøg.
https://dsr.dk/fag-og-udvikling/sygeplejersken/fagbladet-sygeplejersken/sygeplejersken-2010-20